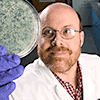

| Copyright (C) All rights reserved. FoodHACCP.com. For more information send email to info@foodhaccp.com TEL) 1-800-986-3934 FAX) 1-253-486-1936 |

| 1 |
| Poster Submission/Competition Major Topic: Control Methods for Food Safety Submit Your abstract (Max. 1000 words) Through poster competition, three presented posters will be awarded |
| Exhibitor's Information Each exhibitor's booth will be assigned at Registration Table (November 14 after 5 PM or November 15, 2016 7:00 -8:00AM) 8ft booth will be available for each exhibitor Electric power will be provided We strongly recommend your poster presentation. To apply poster presentation competition, send email abstract to info@foodhaccp.com There are two free tickets for each exhibitor (Total 3 tickets for conference). Please send us the additional attendee's name For 10-15 min presentation, send your Presentation file to info@foodsafetyconference.org. To reserve Exhibitor booth, send us your information History of Food Safety Conference 10th Int. Conf. (San Francisco) 9th Int. Conf. (Chicago) 8th Int. Conf. (Las Vegas) 7th Int. Conf. (Chicago) 6th Int. Conf. (Chicago) 5th Int. Conf. (Los Angeles) 4th Int. Conf. (Los Angeles) 3rd Int. Conf. (San Francisco) 2nd Int. Conf. (San Francisco) 1st Int. Conf. (San Francisco) |
| Company |
| Your Name |
| Email Address |
| 11th Food Safety Conference Main Topic: Control Methods for Food Safety |
| Conference Place Conference Room, Orleans Hotel 4500 W Tropicana Ave. Las Vegas, NV 89103 TEL) 702-365-7111 Click here for Online Room Reservation |
| Testimonials from Attendees Awesome!!! Enjoyed every Minute. Couldn't have asked for a better learning experience. Rory This conference was Extremely informative well organized and executed. I will continuously attend again. Orlean Excellent selection of speakers. I would definitely recommend this program to others. Carl Excellent Speakers. Surely, I will attend the next one. Well organized. Luis Enjoyed myself.. Great Great Conference Leonard Excellent Experience. I am incredibly happy to have attended. I fully intend on attending next Michael I can get various information about food safety and quality. Takeshi Excellent coverage of topics. I will come again. Tim Excellent 2 days conference very informative presentations. Excellent Resource form all food companies. Susen and more-- |



| Nov. 14 Food Safety Microbiology |
| Nov. 15-16 Main Conference 11th Food Safety |
| Nov. 17-18 HACCP |
| 1 |
| Comments |
| 1 |